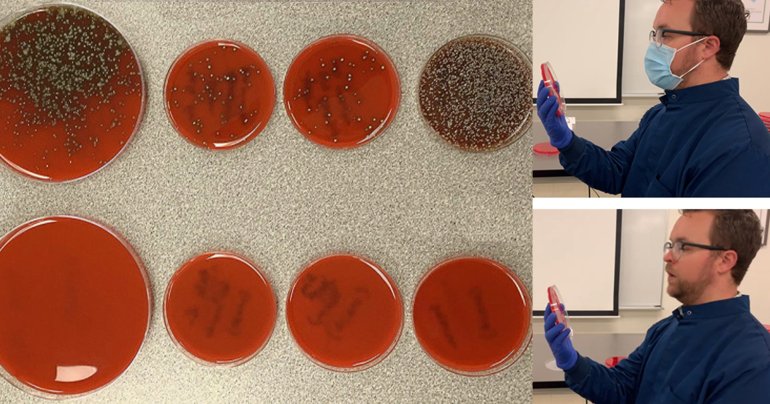

Read
| Health
23/04/2025
ชลธิชา คำแสน | 345 days ago
[บทความ] อาหารเช้าซีเรียลดีจริงหรือ ?
อาหารเช้าซีเรียลที่เสริมด้วยวิตามินและแร่ธาตุอาจเป็นแหล่งใยอาหาร วิตามิน และแร่ธาตุที่มีประโยชน์ต่อร่างกาย แต่ในทางกลับกัน บางชนิดก็ถูกจัดว่าเป็นอาหารแปรรูปขั้นสูง ซึ่งอาจไม่ดีต่อสุขภาพเลยก็ได้ คนไทยส่วนใหญ่มักได้ยินกันมานานแล้วว่า “อาหารเช้าคือมื้ออาหารที่สำคัญที่สุดของวัน” เพราะอาหารมื้อแรกที่ดีสามารถช่วยเพิ่มพลังงานและความมุ่งมั่นในการเริ่มต้นวันใหม่อย่างสดใส แต่ในปัจจุบัน ความหลากหลายของตัวเลือกอาหารเช้าที่มีในท้องตลาดอาจทำให้หลายคนรู้สึกสับสนว่าอะไรคือทางเลือกที่ดีที่สุด โดยเฉพาะอย่างยิ่ง หากคุณเป็นหนึ่งในกลุ่มคนที่นิยมรับประทานซีเรียลเป็นอาหารเช้าเช่นเดียวกับ 53% ของประชากรในสหรัฐอเมริกาที่รับประทานซีเรียลอย่างน้อยสัปดาห์ละครั้ง คุณจะพบว่าซีเรียลในท้องตลาดมีหลากหลายรูปแบบ ไม่ว่าจะเป็นข้าวโอ๊ตกราโนล่า มูสลี่ รำข้าว ข้าวโพดอบแห้ง หรือข้าวพอง ซึ่งทุกยี่ห้อต่างโฆษณาว่ามีประโยชน์ต่อสุขภาพและให้สารอาหารครบถ้วน27/02/2024
รู้จัก Asexual เมื่ออยากมีรัก แต่ไม่อยากมีเซ็กซ์
วันนี้เราจะพาคุณมาเปิดโลก ทำความรู้จักกับคนที่เป็น Asexual อยากมีความรัก แต่ไม่อยากมีเซ็กซ์ รักเธอนะแต่ไม่อยากจริง ๆ รูปแบบของ Asexuality Asexuality มีคำแปลในรูปแบบภาษาไทยว่า “ไม่ฝักใจทางเพศ” คนที่เป็น Asexuality มักมีแนวคิดแบบนี้... ถ้ามีคนรักจะแก้ไขเรื่องนี้ได้ยังไง? อาจจะมีปัญหาในเรื่องของความสมดุลในเรื่องของความต้องการทางเพศ เพราะคนที่ไม่ได้เป็น Asexual ก็ย่อมอยากจะมีเซ็กส์อยู่แล้ว ซึ่งวิธีแก้ปัญหาอาจมีดังนี้ ไม่ว่าคู่ของคุณจะมีความรักแบบไหน สิ่งสำคัญที่สุดเลยก็คือ “ความซื่อสัตย์” การตกลงกันถึงในเรื่องของความสัมพันธ์แบบตรงไปตรงมา ไม่มีการแอบไปทำเรื่องลับ ๆ ลับหลัง เพียงเท่านี้แอดมินเชื่อว่าความรักในแบบของคุณ ก็จะเป็นความรักที่สวยงาม และยืนยาวครับ อ่านบทความเพิ่มเติมได้ที่ OOCA (อูก้า) ปรึกษาปัญหาใจ ***ภูษิต เรืองอุดมกิจ | 766 days ago
Read More27/02/2024
เสริมคาริสมาในแบบคุณเองด้วยวิธีง่าย ๆ
“Charisma ที่แปลว่า” เสน่ห์ มีความแตกต่างกับความสวย ความหล่อโดยสิ้นเชิง คุณอาจจะเคยเจอคนที่ไม่ได้รู้สึกว่าหล่อมากสวยมาก แต่ทำไมมีเสน่ห์น่าดึงดูดจังเลย นั่นแหละครับนิยามของ คาริสม่า แค่เห็นจากไกล ๆ หรือพูดคุยกันเพียงแค่ไม่กี่ประโยคก็รู้สึกหลงใหลได้ปลื้มแล้ว เหมือนโดนมนต์สะกดใจ ต้องทำยังไงนะถึงจะพัฒนาเสน่ห์ในตัวเองได้ มาดูกันครับ ทุกทักษะล้วนเป็นทักษะที่เราสามารถฝึกฝนได้ ไม่เว้นแม้แต่การเสริมสร้างเสน่ห์ให้กับตัวเองเช่นกัน อ่านบทความเพิ่มเติมได้ที่ OOCA (อูก้า) ปรึกษาปัญหาใจ ***ภูษิต เรืองอุดมกิจ | 766 days ago
Read More27/02/2024
Obsessive Love Disorder โรครัก หัวปัก หัวปำ
การรักใครสักคนต้องอยู่บนพื้นฐานของความพอดี แต่ถ้ารักแบบคลั่งมากจนเกินไป ระวังอาจเสี่ยงเป็น “โรคความรักครอบงำ” หรือ Obsessive Love Disorder (OLD) ภาวะนี้คืออาการทางจิตที่เกินคำว่ารัก แต่เป็นความต้องการที่จะครอบงำ ควบคุม และไม่อาจยอมรับการปฏิเสธจากอีกฝ่ายได้เลย โรคความรักครอบงำมักเกิดกับผู้หญิงมากกว่าผู้ชาย ซึ่งจะมีอาการที่บ่งชี้ เช่น สาเหตุของการเกิดโรค “โรคความรักครอบงำ” รักษาได้! ด้วยการใช้ทั้งยา และการทำจิตบำบัด แต่ผู้ป่วยต้องได้รับการวินิจฉัยอย่างละเอียดก่อนว่าเป็นโรค OLD จริง หรือมีความผิดปกติทางจิตอื่น ๆ ร่วมด้วย หากต้นตอของโรคเกิดจากปัญหาในช่วงวัยเด็ก คุณหมออาจต้องวางแผนแนวทางการรักษาอื่น ๆ ร่วมด้วย และไม่ว่าวันนี้ทุกคนกำลังเจอปัญหาทางด้านจิตใจในเรื่องไหนอยู่ แอดมินก็ขอเป็นอีกหนึ่งกำลังใจนะครับ อ่านบทความเพิ่มเติมได้ที่ OOCA (อูก้า) ปรึกษาปัญหาใจ ***ภูษิต เรืองอุดมกิจ | 766 days ago
Read More24/04/2021
เกาหลีใต้เซ็นสัญญากับ Pfizer เตรียมนำเข้าวัคซีน 40 ล้านโดส
เกาหลีใต้เซ็นสัญญากับ Pfizer เพื่อซื้อวัคซีนไวรัสป้องกันไวรัสโควิด-19 จำนวน 40 ล้านโดส เพื่อป้องกันการแพร่ระบาดในอนาคต ทำให้ตอนนี้เกาหลีใต้จะมีวัคซีนจาก Pfizer รวมทั้งหมด 66 ล้านโดส หากนับรวมวัคซีนที่เซ็นสัญญาเพิ่มรอบนี้ จะทำให้เกาหลีใต้มีจำนวนวัคซีนทั้งหมด 192 ล้านโดส โดยมีวัคซีนจาก Moderna, AstraZeneca, Johnson&Johnson และ Novavax ควอน ด็อกชอล (Kwon Deok-Cheol) รมว.สาธารณสุขของเกาหลีใต้รายงานว่า รัฐบาลได้รับวัคซีนโควิด-19 เพียงพอต่อการฉีดให้ประชาชนจำนวน 100 ล้านคน ซึ่งเป็นปริมาณที่มากกว่าประชากรเกาหลีใต้ถึงเท่าตัว และทางรัฐบาลจะดำเนินการฉีดวัคซีนให้คน 12 ล้านคนภายในปลายเดือนมิถุนายนตามสัญญา และจะฉีดวัคซีนให้ประชากรเกือบทั้งหมดภายในเดือนพฤศจิกายน ในปัจจุบันประชากรเกาหลีใต้จำนวน 2.2 ล้านคนจากทั้งหมด 52 ล้านคนได้รับการฉีดวัคซีนโดสแรกแล้ว และรัฐบาลจะทำตามเป้าหมายโดยในเดือนพฤศจิกายนจะประชากรกว่า 70% จะต้องได้รับวัคซีน อ้างอิง: reuters พิสูจน์อักษร : สุชยา เกษจำรัสภควัต ขจิตวิชยานุกูล | 1805 days ago
Read More22/04/2021
ไบเดนมุ่งมั่นผลักดันให้พนักงานสามารถลางานไปฉีดวัคซีนเพื่อเป้าหมาย 200 ล้านโดสใน 100 วัน
วันพุธที่ 21 เมษายน โจ ไบเดนประธานาธิบดีสหรัฐฯ ประกาศให้ธุรกิจขนาดเล็กและองค์กรไม่แสวงหาผลกำไรอนุญาตให้พนักงานลางานไปฉีดวัคซีนโดยยังได้รับเงินเดือน หรือเงินค่าจ้าง ซึ่งรัฐบาลจะช่วยเหลือบริษัทหรือองค์กรเหล่านั้นผ่านการคืนภาษีจากเครดิตภาษีการลาที่ยังได้รับเงินค่าจ้าง (The paid leave tax credit) เพื่อให้สหรัฐฯ ไปถึงเป้าหมายการรับวัคซีน 200 โดสใน 100 วันที่ไบเดนรับตำแหน่งคือในวันพฤหัสสบดีนี้ศิลา วงศ์เจริญ | 1807 days ago
Read More20/04/2021
เทียบให้ดูกันชัด ๆ สวมหน้ากากกับไม่สวมหน้ากากมีผลกับการแพร่เชื้อโรคมากน้อยแค่ไหน
นักจุลชีววิทยาอย่างริช เดวิส (Rich Davis) ได้ทวีตรูปภาพลงในทวิตเตอร์ของเขา เพื่อแสดงให้เห็นว่าการสวมหน้ากากอนามัยสามารถหยุดการแพร่กระจายของละอองในทางเดินหายใจได้อย่างไร โดยเดวิสได้จำลองพฤติกรรมต่าง ๆ ของมนุษย์ในชีวิตประจำวันที่สามารถจะแพร่กระจายเชื้อแบคทีเรียจากคนหนึ่งไปสู่อีกคนหนึ่งได้อย่างเช่น การจาม การร้องเพลง การพูดคุยและการไอ โดยเขาจะใช้วุ้นทดลองที่ใช้สำหรับการตรวจหาเชื้อแบคทีเรีย เพื่อแสดงให้เห็นว่าระหว่างที่เราทำพฤติกรรมแบบนี้ สามารถจะแพร่กระจายเชื้อแบคทีเรียไปได้มากหรือน้อยเพียงใด โดยการทดลองจะแบ่งออกเป็น 2 แบบคือแบบที่ใส่หน้ากากอนามัยและแบบไม่ใส่หน้ากากอนามัย โดยในการทดลองจะแบ่งออกเป็นชัด ๆ ดังนี้ ครั้งแรกเขาจาม 1 ครั้งใส่ตัวทดลอง ผลปรากฏว่าตัวทดลองด้านซ้ายที่ไม่ได้สวมหน้ากากอนามัย จะมีแบคทีเรียผุดขึ้นมามหาศาล ขณะที่ตัวทดลองด้านขวา ไม่มีแบคทีเรียหลุดรอดออกมาเลย เนื่องจากเขาใส่หน้ากากอนามัยนั่นเองครั้งที่สองเป็นการทดลองร้องเพลงเป็นเวลา 1 นาที ผลปรากฏว่าถ้าไม่สวมหน้ากากอนามัย จะมีแบคทีเรียแพร่กระจายออกมาเล็กน้อยครั้งที่สามเป็นการทดลองพูดตามปกติเป็นเวลา 1 นาที ผลปรากฏว่าถ้าไม่สวมใส่หน้ากากอนามัย จะมีแบคทีเรียแพร่กระจายออกมาเล็กน้อยเช่นกัน ขณะที่ถ้าสวมใส่หน้ากากอนามัย ก็ยังคงไม่มีแบคทีเรียหลุดรอดออกมาเช่นเดิมครั้งที่สี่ เป็นการทดลองไอเป็นจำนวน 2 ครั้ง ผลปรากฏว่าถ้าไม่สวมใส่หน้ากากอนามัย จะมีแบคทีเรียแพร่กระจายออกมาค่อนข้างเยอะ ขณะที่ถ้าใส่หน้ากาก ก็จะไม่มีแบคทีเรียหลุดออกมา นี่จึงสรุปได้ว่าพฤติกรรมในชีวิตประจำวันของเราค่อนข้างจะแพร่กระจายแบคทีเรียอยู่มากพอสมควรหากไม่ได้สวมใส่หน้ากากอนามัย แต่เมื่อใดที่สวมใส่หน้ากากอนามัย ก็จะช่วยลดการแพร่กระจายของเชื้อแบคทีเรียได้อย่างมีประสิทธิภาพเลยทีเดียว นอกจากนี้ก็ยังมีการทดลองอีกรูปแบบหนึ่ง ซึ่งเป็นการทดลองว่าการรักษาระยะห่างของบุคคลนั้นสามารถส่งผลต่อการแพร่กระจายของละอองแบคทีเรียได้มากน้อยเพียงไรอีกด้วย โดยการทดลองจะเป็นการทดสอบการไออย่างหนักเป็นเวลาติดต่อกัน 15 วินาที ทั้งแบบที่สวมใส่หน้ากากและไม่สวมใส่หน้ากาก…สรวิชญ์ พระสุจริตวงศ์ | 1809 days ago
Read More20/04/2021
สหรัฐฯ ประกาศเตือนพลเมืองห้ามเดินทางไปยัง 80% ของประเทศทั่วโลก
วันจันทร์ที่ 19 เมษายน กระทรวงการต่างประเทศสหรัฐฯ เผยว่ากำลังมีแผนที่จะอัปเดตสถานะคำแนะนำสำหรับการเดินทางไปยังประเทศต่าง ๆ ในสัปดาห์นี้เพื่อสะท้อนตามสถานการณ์แพร่ระบาดของโควิด - 19 จากศูนย์ควบคุมและป้องกันโรค (CDC) ที่เกิดขึ้นในประเทศต่าง ๆ ในปัจจุบันให้ดีขึ้น โดยจะแจ้งคำแนะนำระดับ 4 : ห้ามเดินทาง (Level 4: Do Not Travel) ไปยังประเทศต่าง ๆ มากถึง 80% ของทั่วโลกศิลา วงศ์เจริญ | 1809 days ago
Read More19/04/2021
ออสเตรเลียเดินหน้าเตรียมอัตราการฉีดวัคซีนให้ประชากรที่อายุมากกว่า 50 ปี!
ประเทศออสเตรเลียวางแผนเร่งการแจกจ่ายวัคซีนโควิด-19 ให้กับประชาชนอายุมากกว่า 50 ปี หลังพบเคสลิ่มเลือดอุดตันในผู้ป่วยอายุน้อยกว่า 50 ปี หลังได้รับวัคซีนของ AstraZeneca สกอตต์ มอร์ริซัน (Scott Morrison) นายกรัฐมนตรีคนปัจจุบันของออสเตรเลียสั่งการให้แจกจ่ายวัคซีนให้กับผู้มีอายุมากกว่า 50 ปี โดยเน้นเป้าหมายที่พนักงานที่ต้องทำหน้าที่ใกล้ชิดกับเชื้อไวรัส รวมถึงผู้สูงอายุ และผู้พิการ โดยจะได้รับการอนุมัติคำสั่งในวันพฤหัสบดีที่จะถึงนี้ ในการปฏิบัติการ รัฐบาลจะจัดตั้งพื้นที่สำหรับฉีดวัคซีน เพื่อรองรับอัตราการฉีดวัคซีนที่จะเพิ่มขึ้นในอนาคต โดยที่ผ่านมาการแจกจ่ายวัคซีนมีความล่าช้าเนื่องจากความกังวลเกี่ยวกับเคสภาวะลิ่มเลือดอุดตันที่เกิดขึ้นในผู้ได้รับวัคซีน AstraZeneca ถึงตอนนี้มีการฉีดวัคซีนให้ประชาชนแล้วจำนวน 1.59 ล้านคน จากประชากรทั้งหมด 25 ล้านคน ออสเตรเลียได้สั่งซื้อวัคซีนของ Pfizer เพื่อที่จะฉีดให้กับผู้ที่มีอายุน้อยกว่า 50 ปี โดยคาดการณ์ว่า จะได้รับวัคซีนในช่วงไตรมาสที่ 4 ในตอนนี้ที่ออสเตรเลีย ประชาชนใช้ชีวิตในสถานการณ์ที่ไม่ร้ายแรงเท่ากับประเทศอื่น ๆ การได้รับวัคซีนจะเป็นปัจจัยสำคัญที่ทำให้มั่นใจได้ยิ่งขึ้นว่า สถานการณ์จะยังคงดีแบบนี้ต่อไปสกอตต์ มอร์ริซัน (Scott Morrison) นายกรัฐมนตรีคนปัจจุบันของออสเตรเลีย นายกรัฐมนตรีกล่าวว่า แม้ประชาชนจะได้รับวัคซีน แต่เขาจะยังคงไม่เร่งรีบในการเปิดชายแดนประเทศ เพื่อป้องกันการแพร่ระบาดของเชื้อไวรัสที่เข้ามาจากคนภายนอก อ้างอิง: reuters พิสูจน์อักษร…ภควัต ขจิตวิชยานุกูล | 1810 days ago
Read More18/04/2021
กว่าหนึ่งปีที่เราได้เผชิญ นี่คือสิ่งที่เรารู้และยังไม่รู้เกี่ยวกับโควิด-19
มนุษยชาติอยู่กับการเรียนรู้สร้างสรรค์วิทยาการใหม่ ๆ ตลอดเวลา มาจนถึงปี 2021 นี้เราส่งยานอวกาศไปสำรวจดาวอังคารกันแล้ว ในอนาคตเราจะมีทัวร์พาคนไปเที่ยวนอกอวกาศ อนาคตอันใกล้เราจะเดินทางกันด้วยความเร็วสูง และรถที่ใช้น้ำมันเป็นเชื้อเพลิงก็กำลังจะหมดไป ใครจะไปคาดคิดว่าวันหนึ่งมนุษย์โลกส่วนใหญ่จะมีโทรศัพท์เคลื่อนที่ติดตัวกันทุกคน เป็นอิสระจากสายระโยงระยาง สามารถพูดคุยกันแบบเห็นหน้าค่าตา แต่การค้นคว้าทุกอย่างเพื่อความสะดวกสบายนั้น กลับไม่ต้องแข่งกับเวลา เหมือนกับการค้นคว้าวัคซีนรักษาโรคร้ายอย่าง โควิด-19สุชยา เกษจำรัส | 1811 days ago
Read More18/04/2021
ชาวแคนาดาเกิดอาการลิ่มเลือดอุดตันเป็นเคสที่ 2 หลังได้รับวัคซีน AstraZeneca
ที่ประเทศแคนาดาพบเคสประชาชนเกิดอาการลิ่มเลือดอุดตันเป็นรายที่ 2 หลังได้รับวัคซีนป้องกันไวรัสโควิด-19 ของ AstraZeneca จากการฉีดวัคซีนทั้งหมด 500,000 โดส เมื่อวันเสาร์ที่ผ่านมา รายงานพบว่า ผู้ได้รับวัคซีนเกิดอาการลิ่มเลือดอุดตันและมีเกล็ดเลือดต่ำหลังจากได้รับวัคซีนเพื่อสร้างภูมคุ้มกันจาก AstraZeneca ซึ่งเป็นกรณีที่เกิดขึ้นได้ยาก และทางรัฐบาลแคนาดายังคงตัดสินใจฉีดวัคซีนดังกล่าวให้กับประชาชนต่อไป ในขณะนี้ผู้ป่วยที่เกิดอาการลิ่มเลือดอุดตันกำลังรับการรักษาอยู่ โดยกระทรวงสาธารณสุขของแคนาดาได้ออกมาให้รายละเอียดเพิ่มเติมว่า ผู้ป่วยมีที่อยู่อาศัยที่รัฐแอลเบอร์ตา (Alberta) รัฐบาลยังคงใช้วัคซีน AstraZeneca ต่อไป เพราะวิเคราะห์ว่า ผลประโยชน์ที่ได้รับคุ้มค่ามากกว่าความเสี่ยงที่จะมีเคสที่ผู้ได้รับวัคซีนเกิดอาการลิ่มเลือดอุดตัน โดยหน่วยงานด้านสุขภาพของแคนาดากล่าวว่า "(เรา)จะตรวจสอบการฉีดวัคซีนโควิด-19 อย่างใกล้ชิด และประเมินเรื่องความกังวลในด้านความปลอดภัย" วันอังคารที่ผ่านมาเป็นวันที่มีเคสผู้ป่วยแรกที่เกิดภาวะลิ่มเลือดอุดตัน โดยในวันต่อมาหน่วยงานด้านสุขภาพของแคนาดาก็ออกมายืนยันว่า จะยังคงฉีดวัคซีน AstraZeneca ต่อไป ในอีกฝั่งหนึ่งก็มีหน่วยงานที่แนะนำว่า ไม่ควรฉีดวัคซีน AstraZeneca ให้กับผู้ที่มีอายุน้อยกว่า 55 ปี และในตอนนี้กำลังอยู่ในขั้นตอนการถกเถียงเกี่ยวกับประเด็นนี้อยู่ อ้างอิง: reuters พิสูจน์อักษร : สุชยา เกษจำรัสภควัต ขจิตวิชยานุกูล | 1811 days ago
Read More18/04/2021
อิสราเอลประกาศให้ผู้คนไม่จำเป็นต้องสวมมาสก์แล้ว หลังรับมือ Covid-19 ได้
ถือเป็นสัญญาณที่ดีของประเทศอิสราเอลหลังจากมีการระบาดของไวรัสโคโรนา เมื่อวันพฤหัสบดีที่ผ่าน มายูลิ เอเดลสไตน์ (Yuli Edelstein) รัฐมนตรีสาธารณสุขประกาศว่าตั้งแต่วันอาทิตย์เป็นต้นไปชาวอิสราเอลจะไม่ต้องสวมหน้ากากอนามัยในที่สาธารณะ ในแถลงการณ์ขณะที่การเฉลิมฉลองวันประกาศอิสรภาพของประเทศกำลังจะสิ้นสุดลง เอเดลสไตน์ กล่าวว่า “เชซี เลวี (Chezy Levy) ผู้อำนวยการใหญ่ของกระทรวงจะลงนามในคำสั่งยุติกฎระเบียบด้านสุขภาพในวันอาทิตย์ แม้ว่าเมื่อต้นเดือนที่ผ่านมาเลวียังคงมีข้อสงสัยและเตือนไม่ให้ยกเลิกคำสั่งดังกล่าว โดยอ้างว่าการใช้หน้ากากอนามัยนอกบ้านมีประสิทธิภาพในการยับยั้งการแพร่ระบาดของ Covid-19 แต่หลังจากได้ปรึกษากับผู้เชี่ยวชาญ จึงตัดสินใจว่าชาวอิสราเอลไม่จำเป็นต้องใช้หน้ากากอนามัยในที่สาธารณะและจะประกาศยกเลิกการสวมหน้ากากอนามัย” หลังจากที่ต้องเผชิญกับการระบาดระลอกที่ 3 อิสราเอลก็ฟื้นตัวอย่างรวดเร็วจากการเร่งแผนการฉีดวัคซีน นับได้ว่าเป็นประเทศที่มีการฉีดวัคซีนต่อหัวเร็วที่สุดในโลก ทำให้ประชาชนกว่าครึ่งได้รับวัคซีนครบถ้วนและรายงานผู้ป่วยรายใหม่และผู้ติดเชื้อร้ายแรงลดลงในระดับที่ไม่เคยได้เห็นมานานหลายเดือน จากข้อมูลล่าสุดของกระทรวงสาธารณสุขที่เปิดเผยเมื่อเย็นวันพฤหัสบดีพบว่ามีรายงานผู้ติดเชื้อโคโรนารายใหม่ 196 ราย และในวันพุธนับตั้งแต่เที่ยงคืนอีก 91 ราย โดยมีจำนวนผู้ติดเชื้อทั้งหมด 836,706 รายนับตั้งแต่การระบาดเริ่มขึ้น โดยอิสราเอลมียอดผู้เสียชีวิตปัจจุบันอยู่ที่ 6,314 คน มีผู้ป่วยที่เข้ารับการรักษาอยู่ 2,945 ราย รวมถึงผู้ป่วย 209 รายที่มีอาการร้ายแรง และอีก 126 รายจำเป็นต้องใช้เครื่องช่วยหายใจ จากการสุ่มตรวจ 55,470 ราย เมื่อวันพุธพบว่ามี 0.4% ที่มีผลเป็นบวกและกระทรวงยังกล่าวอีกว่าชาวอิสราเอล 5,338,967 รายได้รับวัคซีนโคโรนาไวรัสอย่างน้อยหนึ่งเข็มและ 4,961,238…วัชรกุล พัฒนาประทีป | 1811 days ago
Read More17/04/2021
โจ ไบเดนประกาศใช้งบ 1,700 ล้านเหรียญ เพื่อรับมือไวรัสโคโรนาสายพันธุ์ใหม่
ในวันศุกร์ที่ผ่านมาโจ ไบเดน (Joe Biden) ประกาศจะใช้งบ 1,700 ล้านเหรียญเพื่อสนับสนุนศูนย์ควบคุมและป้องกันโรคสหรัฐ (Centers for Disease Control and Prevention) ในการป้องกันและควบคุมการแพร่ระบาดของไวรัสโคโรนาสายพันธุ์ใหม่ การลงทุนในส่วนนี้อยู่ในงบประมาณแผนการช่วยเหลือชาวอเมริกาของประธานาธิบดีโจ ไบเดน ซึ่งตั้งงบประมาณไว้ที่ 1.9 ล้านล้านเหรียญ ซึ่งเน้นการตรวจจับ ตรวจสอบ และบรรเทาทุกข์ เพื่อลดการแพร่ระบาดของเชื้อไวรัส ช่วงเดือนกุมภาพันธ์ที่ผ่านมา หน่วยวิจัยภายในสหรัฐมีสถิติการวิจัยไวรัสโควิด-19 อยู่ที่ 8,000 ตัวอย่างต่อสัปดาห์ แต่เมื่อได้รับงบการวิจัยจากรัฐบาลเพิ่มอีก 200 ล้านเหรียญ จึงได้เพิ่มการศึกษาเพิ่มเป็น 29,000 ตัวอย่างต่อสัปดาห์ สำหรับงบประมาณ 1,700 พันล้านเหรียญที่ใช้ในการสนับสนุนศูนย์ควบคุมและป้องกันโรคสหรัฐฯ จะแบ่งออกเป็นการสนับสนุน 3 จุดใหญ่ ๆ ได้แก่ 1000 ล้านเหรียญ: การเพิ่มตัวอย่างที่ใช้ในการวิจัยไวรัสสายพันธุ์ใหม่400 ล้านเหรียญ: การก่อสร้างศูนย์วิจัยแห่งใหม่300 ล้านเหรียญ: การสร้างโครงสร้างพื้นฐานสำหรับการศึกษาชีวสารสนเทศ (bioinformatics) ซึ่งเป็นการใช้คอมพิวเตอร์ทางชีววิทยาการแพทย์ ในส่วนของยอดการฉีดวัคซีนในสหรัฐอเมริกา พบว่าปัจจุบันมีการฉีดวัคซีนให้กับประชาชนจำนวน 198,317,040 โดส…ภควัต ขจิตวิชยานุกูล | 1812 days ago
Read More16/04/2021
(อัปเดต เม.ย. 64) ข้อควรปฎิบัติตัวเมื่อต้องรับมือ Covid-19
นี่ก็ 1 ปีกว่าแล้วที่มนุษยชาติต้องทนอยู่กับ Covid-19 ไวรัสที่คร่าชีวิตคนทั่วโลกไปมากมาย แม้ในหลาย ๆ ประเทศจะเริ่มผลิตวัคซีนและแจกจ่ายฉีดให้กับประชาชนไปบ้างแล้ว แต่ในประเทศไทยของเราดูเหมือนจะยังไปไม่ถึงจุดนั้น ด้วยเหตุผลอะไรก็ตามแต่ แถมซ้ำหนักเพราะมันเริ่มกลับมาระบาดอีกครั้ง เลยอยากมาเตือนความจำกันอีกสักทีกับข้อควรปฎิบัติตัวเมื่อต้องรับมือ Covid-19 ประเมินตัวเองเบื้องต้นว่ามีเชื้อ Covid-19 หรือไม่ ไม่มีไข้สูงกว่า 37.5 องศาสามารถทานอาหารและดื่มน้ำได้ตามปกติดื่มน้ำได้ไม่ต่ำกว่า 1.5 ลิตรต่อวัน โดยที่ปัสสาวะสีไม่เข้มหายใจได้ปกติ หรือใกล้เคียงปกติ หรือทำแบบทดสอบจากโรงพยาบาลราชวิถีก่อนได้เลย เพื่อลดความเสี่ยงในการแพร่ระบาด และลดการมาโรงพยาบาลโดยไม่จำเป็น คลิกเพื่อทำแบบทดสอบ การปฏิบัติตัวในสถานการณ์ต่าง ๆ เพื่อห่างไกล Covid-19 ตัวเราเองอาจมีเชื้ออยู่ เราจะไม่แพร่เชื้อให้ผู้อื่นได้อย่างไร เมื่อขยี้ตา - จับจมูก - สั่งน้ำมูก - ไอ - มือเปื้อนน้ำลาย - มือปิดปากเวลาไอ ให้รีบล้างมือทันทีหากอยู่ในสถานที่ที่อากาศถ่ายเทไม่ค่อยดี และตัวเรามีประวัติเสี่ยง อย่าทำร้ายคนอื่น ให้เอาตัวเราเองไปอยู่ในทิศทางที่ลมไม่ผ่าน เพื่อไม่ให้พัดสารคัดหลั่งไปสู่คนอื่นหรือหากมีอาการน่าสงสัย ก่อนไปพบแพทย์ ขอให้ทำแบบประเมินความเสี่ยงด้วยตนเองผ่านช่องทาง คลิกที่นี่ ผู้ที่อยู่ข้าง ๆ เราอาจมีเชื้ออยู่…พิทักษ์ จันทร์พลงาม | 1813 days ago
Read More16/04/2021
วางแผนล่วงหน้า! อเมริกาเตรียมฉีดวัคซีนเสริมภูมิคุ้มกัน สำหรับประชาชนที่ได้รับวัคซีนโควิด-19 ในช่วง 1 ปี
รัฐบาลอเมริกาเตรียมพร้อมฉีดวัคซีนเสริมภูมิคุ้มกัน สำหรับประชากร หลังจากได้รับวัคซีนป้องกันโควิด-19 เป็นระยะเวลา 1 ปี เนื่องจากกังวลว่า ภูมิคุ้มกันอาจลดลงเมื่อระยะเวลาผ่านไป ในตอนนี้ทางผู้ผลิตวัคซีนและนักวิจัยกำลังศึกษาเกี่ยวกับประสิทธิภาพของวัคซีนเมื่อเวลาผ่านไปอยู่ และยังไม่มีผลการศึกษาออกมาชัดเจน ดังนั้นหัวหน้าเจ้าหน้าที่วิทยาศาสตร์ของรัฐบาลที่นำโดยประธานาธิบดีโจ ไบเดน (Joe Biden) จึงเตรียมการสำหรับการฉีดวัคซีนกระตุ้นเพิ่มเติม และกล่าวว่า แผนการนี้อาจเริ่มต้นจากประชากรที่เป็นกลุ่มเสี่ยงเป็นลำดับแรก นอกจากนี้หัวหน้าผู้บริหารของ Pfizer ยังแสดงความคิดเห็นในเชิงเห็นด้วยว่า ประชากรอาจต้องรับการฉีดวัคซีนเพิ่มอีกโดส รวมเป็น 3 โดส ภายในระยะเวลา 12 เดือน อีกทั้งยังมีโอกาสที่จะต้องเข้ารับการฉีดวัคซีนทุก ๆ ปี ในตอนนี้ผลการศึกษาพบว่า วัคซีน Moderna และ Pfizer ยังคงมีประสิทธิภาพ 100% ในช่วงระยะเวลา 6 เดือน แต่บริษัทยังไม่ทราบว่า จะคงประสิทธิภาพได้นานที่สุดกี่เดือนหรือกี่ปี ผู้เชี่ยวชาญให้ความเห็นว่า ถึงแม้ประสิทธิภาพของวัคซีนจะยาวนานกว่าที่คาดการณ์ แต่การแพร่ระบาดของไวรัสสายพันธ์ุใหม่ ที่มีการพัฒนาอย่างรวดเร็ว จะทำให้ประชากรต้องเข้ารับวัคซีนเสริมภูมิคุ้มกันเพิ่มเติมรายปี อเมริกาได้ติดตามและเก็บผลสถิติผู้ที่ได้รับวัคซีนจำนวน 77 ล้านราย และพบว่า ในจำนวนนั้น มีประชาชนจำนวน 5,800 ราย…ภควัต ขจิตวิชยานุกูล | 1813 days ago
Read More16/04/2021
Apple จ่ายเงินพิเศษสนับสนุนให้พนักงานลางานไปฉีดวัคซีนโควิด-19
Apple Inc. สนับสนุนให้พนักงานได้รับวัคซีนป้องกันไวรัสโควิด-19 โดยจัดการเวลาสำหรับการนัดหมายและจ่ายค่าลาป่วยสำหรับผู้ที่ได้รับผลข้างเคียงจากการฉีดวัคซีน นับตั้งแต่การแพร่ระบาดของไวรัสที่เริ่มระบาดเมื่อปีที่แล้ว Apple ได้เสนอเวลาหยุดพักให้กับพนักงานที่มีความเสี่ยงในการติดเชื้อโควิด-19 โดยพนักงานหลายคนยังคงทำงานจากที่บ้าน ในขณะที่บริษัทก็ได้ทยอยให้พนักงานในส่วนของหน้าร้านค้าปลีกกลับมาทำงานตามปกติ หลังจากร้าน Apple ทั่วสหรัฐอเมริกาได้เปิดให้บริการอีกครั้ง ในแคลิฟอร์เนียซึ่งเป็นที่ตั้งของ Apple สำนักงานหลักและร้านค้าปลีกอีกมากกว่า 50 แห่ง ผู้ที่มีอายุมากกว่า 16 ปีจะได้รับสิทธิ์ในการเข้ารับการฉีดวัคซีนในวันที่ 15 เมษายน ตามนโยบายของรัฐที่ได้กล่าวก่อนหน้านี้ ในขณะที่รัฐอื่น ๆ อีกหลายแห่งกำลังขยายสิทธิ์การได้รับวัคซีน ด้าน Tim Cook ประธานเจ้าหน้าที่บริหารได้กล่าวกับพนักงานในการประชุม Town Hall เมื่อปลายปี 2020 ว่า “ ไม่มีสิ่งใดทดแทนการทำงานร่วมกันแบบเห็นหน้าได้ แต่เราก็ได้เรียนรู้สิ่งต่าง ๆ มากมายเกี่ยวกับวิธีการทำงานนอกสถานที่โดยไม่เสียผลประโยชน์” ซึ่งในระหว่างนี้จะมีเพียง 15% ของพนักงานทั้งหมดที่ยังคงทำงานที่สำนักงาน และได้มีการประกาศเพิ่มเติมเกี่ยวกับการให้พนักงานกลับเข้ามาทำงานที่สำนักงานตามเดิม แต่ยังไม่มีการแจ้งช่วงเวลาที่ชัดเจน แต่คาดว่าจะเป็นช่วงเดือนมิถุนายนนี้ ในขณะเดียวกันทาง Apple ก็ได้ออกนโยบายสนับสนุนให้พนักงานไปเข้ารับการฉีดวัคซีน เช่นเดียวกันกับบริษัทเอกชนอีกหลาย ๆ แห่ง ที่มีนโยบายสนับสนุนให้พนักงานของตัวเองได้รับวัคซีนไม่ว่าทางใดก็ทางหนึ่ง ทั้งนี้ มีการรายงานจากสำนักข่าว…ซาวานีย์ หะยีลาเต๊ะ | 1813 days ago
Read More16/04/2021
Pfizer เผยเป็นไปได้อาจต้องฉีดวัคซีน COVID-19 เข็มที่ 3 ใน 1 ปีเพื่อการป้องกันเพิ่มเติม
ในช่วงเวลาที่ทั่วโลกได้เร่งฉีดวัคซีนป้องกันโควิด - 19 (COVID-19) ให้กับประชาชนเพื่อลดการแพร่ระบาด การสูญเสียชีวิตและการกู้คืนเศรษฐกิจให้กลับมาดังเดิม ไฟเซอร์ (Pfizer) ผู้ผลิตยาที่ได้รับอนุญาตจำหน่ายวัคซีนป้องกันโควิด – 19 รายแรกในสหรัฐฯ เผยว่ากำลังทดสอบขั้นต่อไปว่าผู้ที่รับวัคซีนครบแล้วสองเข็มจำเป็นต้องรับเข็มที่สามเพิ่มเติมอีกหรือไม่ และมีการข้อมูลเบื้องต้นว่ามีโอกาสเป็นไปได้ศิลา วงศ์เจริญ | 1813 days ago
Read More15/04/2021
ออสเตรเลียสั่งซื้อวัคซีน Pfizer เพิ่มสองเท่า จากความกังวลในวัคซีน AstraZeneca
นายกรัฐมนตรี สก็อต มอร์ริสัน (Scott Morrison) กล่าวเมื่อวันศุกร์ที่ผ่านมา ออสเตรเลียได้เพิ่มคำสั่งซื้อวัคซีน Pfizer เป็นสองเท่า เนื่องจากประเทศต้องการเร่งแผนการฉีดวัคซีน แต่ยังคงมีความกังวลเกี่ยวกับความเสี่ยงของการเกิดลิ่มเลือดอุตันที่เกิดจากผลข้างเคียงของวัคซีน AstraZeneca ก่อนหน้านี้รัฐบาลออสเตรเลียได้จัดเตรียมวัคซีน AstraZeneca จำนวน 50 ล้านโดส ที่ผลิตในประเทศโดยบริษัท Biopharma CSL ซึ่งเพียงพอต่อการฉีดวัคซีนสำหรับประชากรทั้งหมด 25 ล้านคน แต่เนื่องจากความกังวลเกี่ยวกับปัญหาการแข็งตัวของเลือด ออสเตรเลียจึงได้เข้าร่วมกับประเทศต่าง ๆ ในการจำกัดการใช้วัคซีน หน่วยงานสาธารณสุขท้องถิ่นได้แนะนำให้ประชากรที่มีอายุต่ำกว่า 50 ปี ราว 12 ล้านคนใช้วัคซีนจาก Pfizer แทน เป็นผลให้ออสเตรเลียเพิ่มคำสั่งซื้อวัคซีน Pfizer เป็นสองเท่าจากก่อนหน้ารวมทั้งสิ้น 40 ล้านโดส โดยจำนวนวัคซีนดังกล่าวเพียงพอสำหรับจำนวนประชากร 4 ใน 5 ของประชากรทั้งหมด มอร์ริสันกล่าวว่าวัคซีนที่สั่งจะส่งมอบภายในสิ้นปีนี้ โดยการเปลี่ยนแผนการใช้วัคซีนเป็นวัคซีน Pfizer ทำให้แผนที่ต้องการให้ประชากรทั้งหมดฉีดวัคซีนภายในสิ้นเดือนตุลาคมต้องยุติลง มอร์ริสันกล่าวกับสื่อว่า “ไม่ได้มีข้อห้ามในการฉีดวัคซีนจาก AstraZeneca สำหรับผู้ที่มีอายุมากกว่า 50 ปี…วัชรกุล พัฒนาประทีป | 1814 days ago
Read More15/04/2021
เดนมาร์กเลิกใช้วัคซีน AstraZeneca เป็นประเทศแรกของโลก
เมื่อวันพุธที่ผ่านมาเดนมาร์กกลายเป็นประเทศแรกที่หยุดการใช้งานวัคซีน AstraZeneca เนื่องจากวัคซีนมีความเชื่อมโยงกับภาวะการอุดตันของเลือดซึ่งแม้ว่าจะเกิดขึ้นได้ยาก แต่ร้ายแรงมาก การตัดสินใจดังกล่าวทำให้แผนการฉีดวัคซีนให้กับประชาชนในเดนมาร์กอาจเลื่อนออกไปจนถึงต้นเดือนสิงหาคม จากแผนเดิมที่จะเสร็จสิ้นวันที่ 25 กรกฏาคม และคาดว่าเดนมาร์กจะกลับมาใช้วัคซีน Johnson & Johnson ซึ่งก่อนหน้านี้ได้ระงับการใช้ไป เนื่องจากมีความกังวลว่าวัคซีนมีความเชื่อมโชงกับภาวะลิ่มเลือดอุดตัน องค์กรยาแห่งสหภาพยุโรปกล่าวเมื่อสัปดาห์ที่แล้วว่าพบความเชื่อมโยงที่เป็นไปได้ระหว่างวัคซีน AstraZeneca กับการอุดตันของหลอดเลือดดำในสมอง (CVST) แต่ความเสี่ยงของการเสียชีวิตจาก Covid-19 นั้นมากกว่าความเสี่ยงต่อการเสียชีวิตจากผลข้างเคียง แต่องค์กรปล่อยให้แต่ละรัฐบาลทำการประเมินความเสี่ยงและตัดสินใจว่าจะมีการใช้งานวัคซีนอย่างไร โซเรน บรอสตอม (Soren Brostrom) หัวหน้าหน่วยงานด้านสุขภาพของเดนมาร์กกล่าวว่า “ผลการวิจัยแสดงให้เห็นแล้วว่าวัคซีน AstraZeneca มีความเกี่ยวข้องกับการอุดตันของเลือด ดังนั้นเราจึงตัดสินใจยุติการใช้วัคซีน AstraZeneca” และเสริมว่าจากการศึกษาร่วมกันโดยอาศัยข้อมูลด้านสุขภาพของเดนมาร์กและนอร์เวย์คาดว่าหนึ่งใน 40,000 คนที่ได้รับการฉีดวัคซีน AstraZeneca อาจได้รับผลข้างเคียงที่ร้ายแรง โดยไม่พบความเกี่ยวข้องกับอายุหรือเพศ ทาง AstraZeneca เคารพในการตัดสินใจของเดนมาร์กและจะยังคงให้ข้อมูลต่างๆต่อไปเพื่อช่วยในการตัดสินใจในอนาคต เดนมาร์กเป็นประเทศแรกที่ระงับการใช้วัคซีน AstraZeneca ทั้งหมดในเดือนมีนาคมเนื่องจากปัญหาด้านความปลอดภัยของผู้ได้รับวัคซีน แม้ว่าหลาย ๆ ประเทศในยุโรปเริ่มกลับมาใช้งาน AstraZeneca อีกครั้ง ในบางประเทศมีการจำกัดอายุผู้ใช้งาน โดยส่วนใหญ่ใช้งานในผู้ที่มีอายุมากกว่า 50-60 ปีขึ้นไป อ้างอิง Reuters…วัชรกุล พัฒนาประทีป | 1814 days ago
Read More13/04/2021
การศึกษาชี้ Sinovac สามารถป้องกันไวรัสกลายพันธุ์ 3 สายพันธุ์ได้
หลังจากที่จีนออกมายอมรับถึงประสิทธิภาพที่ต่ำของวัคซีน Sinovac ซึ่งเป็นวัคซีนที่พัฒนาขึ้นโดยบริษัทยาจากประเทศจีน ทำให้เกิดการตั้งคำถามและมีความกังวลเกี่ยวกับประสิทธิภาพในการป้องกันไวรัสกลายพันธุ์สายพันธุ์อังกฤษ B.1.1.7 ที่ขณะนี้กำลังระบาดในไทยได้หรือไม่ ในวันที่ 10 มีนาคม ดิมาส แคนวาส (Dimas Convas) ผู้อำนวยการบริษัท Butantan ได้ออกมากล่าวถึงประสิทธิภาพของวัคซีน Sinovac ที่สามารถป้องกันไวรัสกลายพันธุ์ 3 สายพันธุ์ ได้แก่ ไวรัสสายพันธุ์อังกฤษ (B.1.1.7) ,ไวรัสสายพันธุ์แอฟริกาใต้ (B.1.351) และไวรัสสายพันธุ์บราซิล (B.1.1.28) ที่เกิดการกลายพันธุ์จากตัวแปร P.1 จากรัฐมาเนาส์ และ P.2 จากริโอเดจาเนโร การศึกษาโดยบริษัท Butantan ร่วมกับ University of São Paulo (USP) ได้ทำการรวบรวมกลุ่มอาสาสมัครจำนวน 25 คน จากกลุ่มทดลองที่ได้รับวัคซีน Sinovac ในบราซิล จำนาวน 9,000 คน เพื่อทดสอบประสิทธิภาพและความปลอดภัยของวัคซีน เป็นการตรวจสอบให้แน่ใจว่าวัคซีนสร้างแอนติบอดีต่อสายพันธุ์เหล่านี้หรือไม่ โดยการศึกษาฉบับเต็มจะประกอบด้วยกลุ่มตัวอย่างจำนวนมากขึ้นซึ่งอยู่ระหว่างการวิเคราะห์ แม้ว่าวัคซีน Sinovac…วัชรกุล พัฒนาประทีป | 1816 days ago
Read MorePR Partners
See All03/04/2026
ภูษิต เรืองอุดมกิจ | 7 hours ago
Vgadz เปิดตัว “RingConn Gen 2 Air” แหวนอัจฉริยะเบาที่สุด พร้อมส่วนลดพิเศษ
วีแกดซ์ (Vgadz) เปิดตัว “RingConn Gen 2 Air” แหวนอัจฉริยะรุ่นล่าสุดที่สร้างมาตรฐานใหม่ให้วงการ ภายใต้คอนเซปต์ “Smart Ring for Everyone” โดดเด่นด้วยดีไซน์ที่เน้นความบางเบาและการใช้งานที่คุ้มค่าในระยะยาว เบาที่สุดและใส่สบาย 24 ชั่วโมง RingConn Gen 2 Air ถูกออกแบบมาเพื่อแก้ปัญหาความอึดอัดจากการสวมใส่ Smart Watch โดยเฉพาะรุ่นนี้มีความบางเพียง 2 มิลลิเมตร และน้ำหนักเบาสุดขีดเพียง 2.5 กรัม03/04/2026
ทรู-โลตัส พลิกลานหน้าศูนย์การค้าสู่ “True Alpha Urban Ground” แลนด์มาร์กกีฬาอัจฉริยะเพื่อความเท่าเทียม
ทรู คอร์ปอเรชั่น ผนึกกำลัง โลตัส เปิดตัว “True Alpha Urban Ground” ณ โลตัส บางนา สนามบาสเกตบอลต้นแบบที่เปลี่ยนพื้นที่หน้าศูนย์การค้าให้เป็น “พื้นที่สีขาว” ใจกลางเมือง มุ่งสร้างโอกาสที่เท่าเทียมในการเข้าถึงการออกกำลังกาย พร้อมยกระดับคุณภาพชีวิตและสร้างสังคมที่ห่างไกลยาเสพติด โปรเจกต์นี้เป็นการผสาน กีฬา ไลฟ์สไตล์ และเทคโนโลยี เข้าด้วยกันอย่างลงตัว โดยนำนวัตกรรมอัจฉริยะมาอำนวยความสะดวกและรักษาความปลอดภัยแบบครบวงจร อาทิ : คุณโอลิเวอร์ กิตติพงษ์ วีระเตชะ ผู้บริหารจากทรู ระบุว่า ทรูเชื่อมั่นในพลังของกีฬาที่เป็นรากฐานของการเติบโตทั้งร่างกายและจิตใจ การนำเทคโนโลยี AI และเครือข่ายมาใช้ในพื้นที่สาธารณะนี้ จะช่วยลดความเหลื่อมล้ำและสร้างภูมิคุ้มกันให้เยาวชนใช้เวลาว่างให้เป็นประโยชน์ ขณะที่ คุณเบญจวรรณ อ่องศรี จากซีพี แอ็กซ์ตร้า กล่าวเสริมว่า สนามนี้คือส่วนหนึ่งของแนวคิด “Happy Mall” ที่เปลี่ยนโลตัสให้เป็น Happy Community Space ศูนย์รวมการกิน ชอป เที่ยว และการใช้ชีวิตที่มีความสุขของคนในชุมชน ในพิธีเปิดได้รับเกียรติจากนายกสมาคมกีฬาบาสเกตบอลแห่งประเทศไทย พร้อมเหล่าศิลปินและนักกีฬาชื่อดัง อาทิ…ภูษิต เรืองอุดมกิจ | 12 hours ago
Read More02/04/2026
“ไมโครซอฟท์-ซีพี-ทรู” ผนึกกำลังขยับหมากรบ AI เปลี่ยนไทยให้เป็น ‘ศูนย์กลางนวัตกรรม’ แห่งอาเซียน
ในการประชุมครั้งสำคัญเมื่อวันที่ 2 เมษายน 2026 ภาพความร่วมมือระหว่างยักษ์ใหญ่ระดับโลกอย่าง ไมโครซอฟท์ คอร์ปอเรชัน และผู้นำธุรกิจไทยอย่าง เครือเจริญโภคภัณฑ์ (เครือซีพี) พร้อมด้วย ทรู คอร์ปอเรชั่น ไม่ได้เป็นเพียงการพบปะทางธุรกิจทั่วไป แต่คือการขยับหมากครั้งสำคัญที่ส่งสัญญาณถึงการเปลี่ยนผ่านของประเทศไทยสู่การเป็นศูนย์กลางเทคโนโลยีและนวัตกรรมของอาเซียนอย่างเต็มตัว AI-First และการมาถึงของ Agentic AI หนึ่งในประเด็นที่น่าสนใจที่สุดจากการหารือคือแนวคิดการก้าวสู่การเป็น AI-first organization ซึ่งไม่ใช่เพียงการนำเทคโนโลยีมาเสริม แต่คือการวางรากฐานองค์กรโดยมี AI เป็นหัวใจหลัก สิ่งที่สะท้อนให้เห็นถึงความล้ำหน้าคือการพูดถึง Agentic AI ซึ่งก้าวข้ามขีดจำกัดของ AI ทั่วไปที่ทำหน้าที่เพียงตอบคำถาม ไปสู่การเป็น "ตัวแทน" ที่สามารถช่วยตัดสินใจและดำเนินกระบวนการทำงานอัตโนมัติได้อย่างมีประสิทธิภาพ เทคโนโลยีนี้จะส่งผลกระทบโดยตรงต่อโครงสร้างพื้นฐานและการดำเนินงานขององค์กร โดยเน้นการวิเคราะห์ข้อมูลเชิงลึกเพื่อเพิ่มประสิทธิภาพในทุกมิติ สำหรับประเทศไทย นี่คือโอกาสที่จะยกระดับโซลูชันบนโครงสร้างพื้นฐานดิจิทัลที่แข็งแกร่งขึ้นจากการร่วมมือกันของทั้งสองฝ่าย ยุทธศาสตร์ Smart City และการเรียนรู้จากต้นแบบโลก นายศุภชัย เจียรวนนท์ รองประธานอาวุโส เครือเจริญโภคภัณฑ์ ได้ฉายภาพอนาคตที่เทคโนโลยีจะกลายเป็นเนื้อเดียวกับชีวิตมนุษย์ผ่าน Smart City โดยระบุว่าโอกาสเชิงยุทธศาสตร์ของไทยอยู่ที่ 3 เสาหลัก การมองหาต้นแบบจาก สิงคโปร์…ภูษิต เรืองอุดมกิจ | 1 days ago
Read More27/03/2026
“บางกอกแอร์เวย์ส” กางโรดแม็ปปี 2026 เปิดเกมรุกระยะยาว พร้อมเตรียมปรับขึ้นค่าตั๋ว หลังราคาน้ำมันพุ่ง เริ่ม 1 เม.ย. นี้
บริษัท การบินกรุงเทพ จำกัด (มหาชน) หรือสายการบินบางกอกแอร์เวย์ส (BA) ประกาศทิศทางยุทธศาสตร์ครั้งสำคัญประจำปี 2026 เตรียมพร้อมรุกตลาดการบินระดับภูมิภาคอย่างเต็มกำลัง โดยมุ่งเน้นการบริหารงานแบบครบวงจรเพื่อสร้างความแข็งแกร่งในระยะยาว นายพุฒิพงศ์ ปราสาททองโอสถ กรรมการผู้อำนวยการใหญ่ พร้อมทีมผู้บริหารระดับสูง ได้ร่วมกันแถลงวิสัยทัศน์ใหม่ภายใต้แนวคิด “Leading Aviation with Responsibility, Delivering Services with Sustainability” หรือ “ผู้นำด้านธุรกิจการบินอย่างรับผิดชอบ ส่งมอบบริการที่ยั่งยืน” สะท้อนกลยุทธ์การดำเนินธุรกิจการบินแบบครบวงจร เพื่อรองรับการเติบโตอย่างมั่นคงและยั่งยืนในระยะยาว นายพุฒิพงศ์ ปราสาททองโอสถ กรรมการผู้อำนวยการใหญ่ บริษัท การบินกรุงเทพ จำกัด (มหาชน) กล่าวว่า ในปีที่ผ่านมา ตลาดนักท่องเที่ยวจากยุโรปมีการเติบโตอย่างต่อเนื่อง โดยเฉลี่ยเพิ่มขึ้นประมาณ 11% ขณะที่แนวโน้มอุตสาหกรรมการบินในปี 2026 จากข้อมูลของสมาคมขนส่งทางอากาศระหว่างประเทศ (IATA) ณ เดือนมกราคม 2026 การขนส่งปริมาณผู้โดยสาร (RPK) ทั่วโลกเพิ่มขึ้นประมาณ 3.8% โดยเฉพาะภูมิภาคเอเชียแปซิฟิก เติบโตที่ 4.4% อย่างไรก็ตาม สถานการณ์ความตึงเครียดด้านภูมิรัฐศาสตร์ในปัจจุบัน อาจส่งผลกระทบต่อการเดินทางระหว่างประเทศในระยะนี้ บริษัทฯ จึงยังคงติดตามสถานการณ์อย่างใกล้ชิด พร้อมปรับกลยุทธ์การดำเนินงานให้สอดคล้องกับสถานการณ์ที่เปลี่ยนแปลง เพื่อให้การดำเนินงานและการให้บริการแก่ผู้โดยสารเป็นไปอย่างต่อเนื่องและมีประสิทธิภาพ นายพุฒิพงศ์ กล่าวต่อว่า ยอดการสำรองที่นั่งล่วงหน้าของบริษัท ฯ ณ วันที่ 16 มีนาคม 2026 สำหรับการเดินทางตั้งแต่เดือนเมษายนถึงกันยายน 2026 เพิ่มขึ้นจากช่วงเดียวกันของปีก่อน 1% โดยอัตราการจองบัตรโดยสารล่วงหน้าไตรมาสที่ 2 ลดลง 3% ขณะที่ไตรมาสที่ 3 เติบโต 9% ในด้านการยกระดับศักยภาพโครงสร้างพื้นฐาน บริษัท ฯ คาดว่าจะเริ่มดำเนินการก่อสร้างโครงการปรับปรุงสนามบินสมุยในไตรมาส 2 ปี 2026 เพื่อเพิ่มขีดความสามารถในการรองรับผู้โดยสาร 6 ล้านคนต่อปีพร้อมเพิ่ม Boarding Gates จาก 7 เป็น 11 ขยายพื้นที่เชิงพาณิชย์เป็น 4,000 ตารางเมตร และเพิ่มเคาน์เตอร์เช็กอินพร้อมเครื่องเช็กอินด้วยตนเองอัตโนมัติรวม 40 จุด โดยมีกำหนดแล้วเสร็จในปี 2573 ขณะเดียวกัน สนามบินตราดได้ขยายทางวิ่ง (Runway) เป็นความยาว 2,000 เมตรเรียบร้อยแล้ว และอยู่ระหว่างการก่อสร้างทางขับเคลื่อนอากาศยาน (Taxiway) และลานจอดอากาศยานจำนวน 3 จุด เพื่อรองรับอากาศยานแบบไอพ่น อาทิ แอร์บัส A320 โดยคาดว่าจะแล้วเสร็จภายในระยะเวลา 1 ปี ด้านการบริหารจัดการฝูงบิน ในปีนี้สายการบินบางกอกแอร์เวย์สคาดว่าจะมีเครื่องบินจำนวน 22 - 26 ลำ ซึ่งฝูงบินปัจจุบันประกอบด้วยเครื่องบินแบบ แอร์บัส A320 จำนวน 1 ลำ แอร์บัส A319 จำนวน 11 ลำและ ATR 72-600 จำนวน 10 ลำ โดยมีแผนสั่งซื้อเครื่องบินแบบ ATR 72-600 ใหม่จำนวน 12 ลำ ซึ่งจะรับมอบ 2 ลำแรกในไตรมาส 4 ปีนี้ และทยอยรับมอบไปจนถึงปี 2028 นายพุฒิพงศ์ ยังได้เปิดเผยอีกว่า…รัตนาภรณ์ ศรีนวลจันทร์ | 7 days ago
Read More